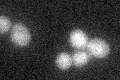
YKR101W
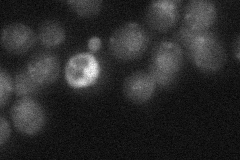
YKR101W
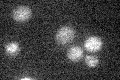
YKR101W

View description
Protein involved in repression of transcription at the silent mating-type loci HML and HMR; recruitment to silent chromatin requires interactions with Orc1p and with Sir4p, through a common Sir1p domain; binds to centromeric chromatin
Localization:
Intensity:
Fold change:
Significance:
-
C’ GFP library in SD
below threshold17.24 -
N' NOP1pr-GFP in SD

nucleus28.7079 -
N' TEF2pr-mCherry in SD

nucleus,nucleolus18.4851 -
N' NATIVEpr-GFP in SD
punctate,nucleus21.583 -
N' TEF2pr-VC and Cyto-VN in SD

#N/A0 -
C’ GFP library in SD+DTT

cytosol17.871.03No -
C’ GFP library in SD+H2O2

cytosol18.681.08No -
C’ GFP library in Starvation Media
cytosol15.930.92No -
C’ GFP library on the background of Pup2-DaMP

below threshold -
C’ GFP library on the background of CCT mutant

below threshold17.54421.01726No
